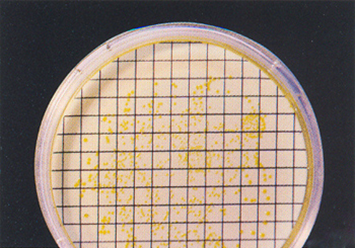

MANNITOL SALT BROTH es la versión en caldo del Mannitol Salt Agar de Chapman, y sirve para enriquecimiento selectivo de Staphylococcus aureus
Caldo de enriquecimiento selectivo para estafilococos. Enumeración por los métodos NMP ó MF.
COMPOSICIÓN
- Extracto de carne 1,000 g
- Peptocomplex 10,000 g
- Cloruro sódico 75,000 g
- Mannitol 10,000 g
- Rojo fenol 0,025 g
Colonias amarillas de Staphylococcus aureus, en cartón absorbente, con medio virado del rojo al amarillo.
(Fórmula por litro)
pH final: 7,4 ± 0,2
PREPARACIÓN
Disolver 96 gramos en 1 litro de agua destilada.
Autoclavar a 121 ºC durante 15 minutos.
PARA USO EXCLUSIVO EN LABORATORIO
AGITE EL BOTE ANTES DE USAR.
MANTENGA EL BOTE BIEN CERRADO EN LUGAR SECO, FRESCO Y OSCURO
DESHIDRATADO CODIGO: DMT165
CONTROL DE CALIDAD DEL MEDIO
Realizado en nuestro laboratorio; es prudente repetirlo en su laboratorio siempre que varíen las condiciones (más de 3 meses sin usar, tras desinfectar laboratorio, tras conservar a alta Tª, cuando adquiere aspectos extraños aunque no haya llegado la fecha de caducidad teórica de la etiqueta,…)
DESHIDRATADO: Polvo fino, Rosa
PREPARADO: Estéril, Rojo
CONTROL DE CRECIMIENTO 24-48 h a 37°C aproximadamente:
- Staphylococcus aureus MKTA 6538P, Correcto, Medio amarillo.
- Staphylococcus epidermidis MKTA 12228, Correcto, Medio anaranjado.
PRESENTACIÓN: TUBOS PREPARADOS, FRASCOS PREPARADOS, VIALES MF, KITS P/A, MEDIO DESHIDRATADO.
MODO DE EMPLEO E INTERPRETACIÓN DE RESULTADOS
Sembrar 1 ml de la muestra en un tubo de 9 ml. O bien 10 ml en un frasco de 100 ml. O bien verter un vial de 2 ml en un cartón absorbente colocado en una placa Petri de 55 mm Ø y después depositar la membrana de filtración utilizada. Incubar a 37 ºC aproximadamente, 24-48 horas.
Los tubos amarillos contienen presuntamente S. aureus. Los tubos turbios no amarillos contienen presuntamente otros estafilococos. Sembrar en agar Mannitol para aislar colonias e identificarlas. En filtración de membrana, las colonias amarillas son presuntos S. aureus y las rojas son presuntamente otros estafilococos. Confirmar la coagulasa con el látex inmediato KWD094.
https://www.microkit.es/fichas/MANNITOL-SALT%20BROTH.pdf
El usuario final es el único responsable de eliminar los microorganismos de acuerdo con la legislación medioambiental vigente. Autoclavar antes de desechar a la basura.
Si desea más información sobre nuestros MANNITOL SALT BROTH, rellene nuestro formulario de contacto http://www.medioscultivo.com/contacto . O si lo prefiere póngase en contacto con nosotros a través de nuestro correo electrónico microkit@microkit.es o por teléfono en el nº 91-897 46 16


